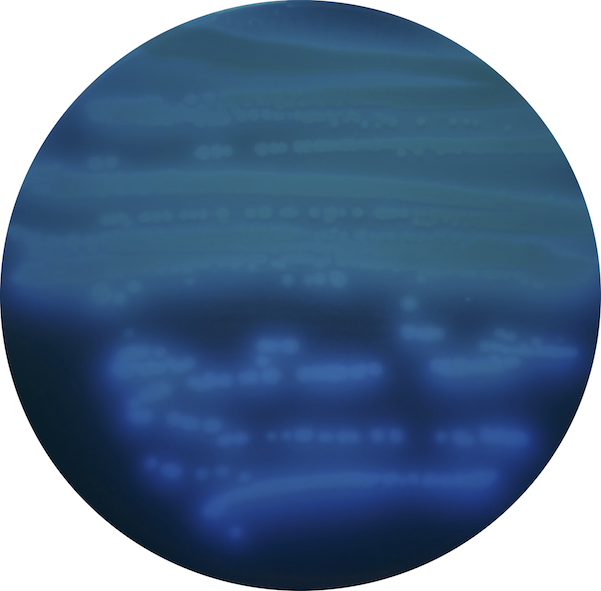

Iron and Bacterial Pathogenesis
at the
University of Maryland School of Pharmacy
Our Research
Iron is an essential metallonutrient for nearly all living organisms and represents a primary driver of host-pathogen interactions. During infection, pathogenic bacteria must be able to manage their requirement for iron with its potential for toxicity. This is achieved through a combination of iron uptake and regulatory pathways, which function to maintain iron homeostasis. The focus of our laboratory’s research is to understand how these systems mediate iron homeostasis and contribute to bacterial pathogenesis. Our studies are currently focused on Pseudomonas aeruginosa and Staphylococcus aureus, opportunistic pathogens of significant concern for hospital-acquired infections and in cystic fibrosis patients. We use a multidisciplinary approach to determine how iron homeostasis is mediated by these pathogens, as well as the impact of these systems on pathogenesis.
Ongoing Projects